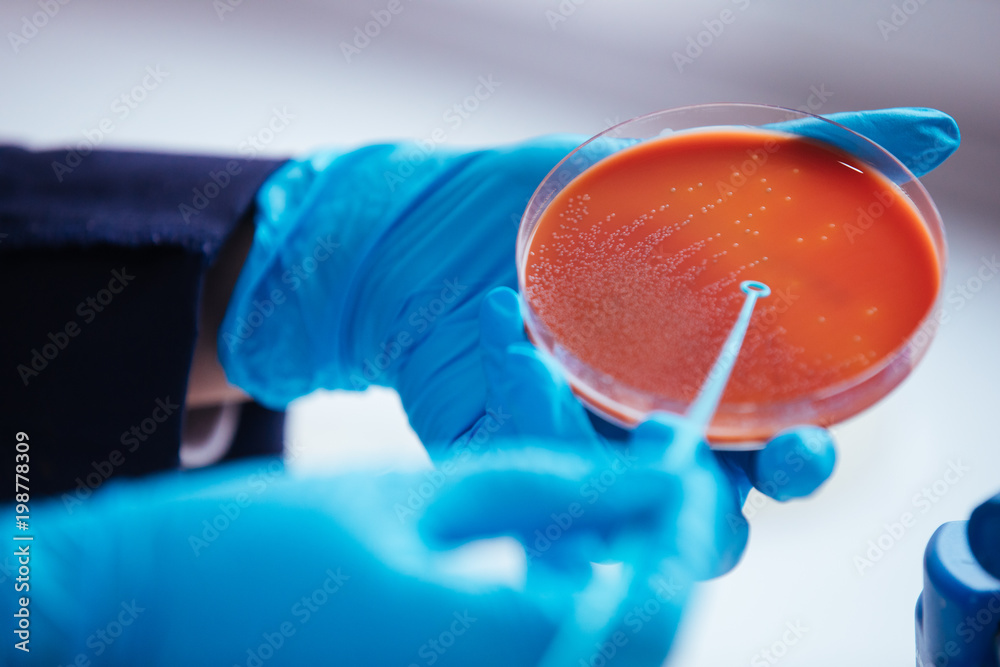

Sticker
Sticker
Enter the dimensions of the photo and set the frame by clicking below the left mouse button and moving the frame.



 The maximum width of print is 134cm. Larger prints than this value will be divided and printed on several rolls of wallpaper. If you have any request for positions of dividing your image, please message us when placing an order.
Wallpaper Murals has overlap
The maximum width of print is 134cm. Larger prints than this value will be divided and printed on several rolls of wallpaper. If you have any request for positions of dividing your image, please message us when placing an order.
Wallpaper Murals has overlap "Ultra mat" has a water-activated adhesive. Forget about difficult bonding. Simply soak in water or spray water on the back of the wallpaper to enjoy easy stick. The Ultra mats come with a 20 year warranty.
Our prints are odorless, made with original inks on premium brand wallpaper murals. You get a toxin-free, eco-certified, and environmentally friendly product.
We supported over 2500+ artists on WallsHeaven!
We’ve printed more than 39 000 m2 m² of wallpaper murals!

PayPal payments guarantee you a full refund. All our customers who were not satisfied received a refund through PayPal, even if they had issues with the assembly.
100% of our customers who requested a refund received it. Over the past 10 years, we have fulfilled a very large number of orders, and only 0.03% of customers were dissatisfied. You could say that 99% of our customers received their prints without any complaints.
Ultra smooth and durable mural ideal for home, apartment and office. Any graphics printed on ULTRA MAT look stunning and the colors remain stable for up to 20 years! The material provides excellent print quality and contains no PVC, so it is breathable. The wallpaper has an adhesive layer, which is ready for immediate use, even by unskilled persons. approx. 215 µm thick. approx. 195 g/m2 heavy
Key benefits
"Latex interlining, which was created from combining cellulose with polyester non-woven fabric with a latex binder. We get more juicy colors. The wallpaper is scratch and tear resistant by exceptional durability against scratches and fading. Perfect for home, office and public spaces. Wallpaper printing is carried out based on inks with safety and ecological, thanks to which you receive an odorless, safe and environmentally friendly product. We also offer printable wallpapers dedicated to schools, health care facilities and certified restaurants. The composition of the wallpaper does not contain PVC, heavy metals, formaldehyde, plasticizers, solvents and fiberglass (DoP declaration). The wallpaper has a flame retardant certificate and a hygienic certificate. APPLICATION: ●assembly indoors, ●creating your own photo wallpapers, ●wall graphics (material to be used in commercial construction (shopping centers, offices, etc.), individual and public use (cinema, museums, universities, offices, etc.)."
Wallpaper Mural Vinyl Premium Mat is highest brilliance, photorealistic print quality and good scratch resistance with non-woven construction for easier removal from substrate. Is Designed for high humidity like bathroom, or for high traffic places like restaurants with antibacterial shields, or room to make soundproofing and more warm by one top thickest wallpaper in the world. The wallpaper is the best combination of the world to get best quality, with super flexible and resists material on scratch. Easy put on the wall and 10 years warranty
Geek Details: